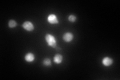
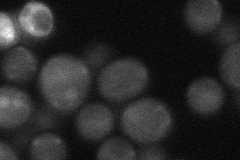

View description
Essential protein involved in the processing of pre-rRNA and the assembly of the 60S ribosomal subunit; interacts with ribosomal protein L11; localizes predominantly to the nucleolus; constituent of 66S pre-ribosomal particles
Localization:
Intensity:
Fold change:
Significance:
-
C’ GFP library in SD
nucleus130.18 -
N' NOP1pr-GFP in SD

punctate,nucleus147.457 -
N' TEF2pr-mCherry in SD

nucleus58.9397 -
N' NATIVEpr-GFP in SD
cytosol28.4064 -
N' TEF2pr-VC and Cyto-VN in SD

#N/A0 -
C’ GFP library in SD+DTT

nucleus91.070.69No -
C’ GFP library in SD+H2O2

nucleus96.810.74No -
C’ GFP library in Starvation Media

punctate, nucleusN/AN/AYes -
C’ GFP library on the background of Pup2-DaMP

nucleus -
C’ GFP library on the background of CCT mutant

nucleus119.1320.915106No
